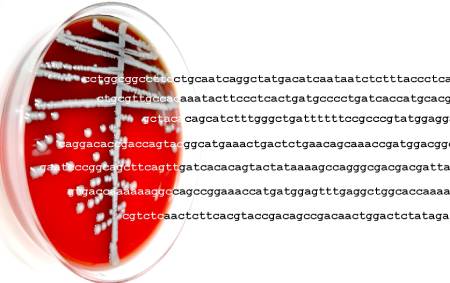
Blood Agar petri dish with sequence read coming from bacteria on the plate.

Note: the training is no longer accredited for continuing education.
Training is available for all levels of experience and learners can choose to build from one level to the next:
- Beginner: CM workforce that does not have NGS equipment.
- Intermediate: CM workforce that acquired a NGS sequencer during the COVID-19 pandemic.
- Advanced: CM workforce that had NGS experience pre-pandemic and is actively involved in sequencing.
- Expert: Bioinformatics partners who already work on human genomics and would benefit from education on infectious disease applications of NGS. The content is intermediate and advanced.
Speaker: Frederic D. Bushman
This course will focus on the fundamentals of pathogen genomics including defining key terms and discussing components of the genome. The impact of mutations on phenotypes and protein expressions will also be discussed.
Review of Pathogen Genomics—Part 2
Speaker: Frederic D. Bushman
Part 2 of this course, focuses on the fundamentals of pathogen genomics, including defining key terms and discussing components of the genome. The impact of mutations on phenotypes and protein expressions will also be discussed.
Connecting the Genome to Molecular Diagnostics
Speaker: Rosemary She
An overview of molecular methods, from principle to clinical application, will be provided in detail. Strengths and limitations of various approaches will be discussed.
The Evolution of NGS Technologies—Part 1
Speaker: Mendy Poulter
Part 1 of this training—With the advent of NGS, it is crucial to understand the evolution of molecular diagnostics, starting from Sanger sequencing through NGS. Additional topics include the appropriate use of long and short reads, as well as understanding commonly used NGS technologies and platforms.
The Evolution of NGS Technologies- Part 2
Speaker: Mendy Poulter
Part 2 of this training—With the advent of NGS, it is crucial to understand the evolution of molecular diagnostics, starting from Sanger sequencing through NGS. Additional topics include the appropriate use of long and short reads, as well as understanding commonly used NGS technologies and platforms.
Overview of Whole Genome Sequencing
Speaker: Nick Moore
Whole genome sequencing (WGS) is more frequently being used in outbreak scenarios and for the prediction of antibiotic resistance. This section discusses the history of WGS, including its predecessors and the methodology behind WGS.
Overview of Amplicon-Based NGS
Speaker: Paige Larkin
Amplicon-based NGS is one of the more commonly used types of NGS in the clinical microbiology lab. In this section, participants will learn the principles of amplicon-based NGS and its applications, limitations and impact on patient care.
Overview of Shotgun Metagenomic Sequencing
Speaker: Robin Patel
As targeted and shotgun metagenomic sequencing increase in popularity, their advantages and limitations are being defined. Real clinical cases and impact will be shared.
Application of Genomic Epidemiology for Surveillance and Infection Prevention in Healthcare Settings—Part 1
Speaker: Marie-Claire Rowlinson
Part 1 of this training—After learning about the principles and limitations of NGS, participants will discover how NGS is used in epidemiology studies and infection control in hospital settings. Participants will be walked through different clinical scenarios where NGS can be used.
Application of Genomic Epidemiology for Surveillance and Infection Prevention in Healthcare Settings—Part 2
Speaker: Marie-Claire Rowlinson
Part 2 of this training—After learning about the principles and limitations of NGS, participants will discover how NGS is used in epidemiology studies and infection control in hospital settings. Participants will be walked through different clinical scenarios where NGS can be used.
NGS Data Collection and Storage
Speaker: Xiaowu Gai
Data collection and storage are crucial components of NGS. Important considerations, including amount of data, storage options, instrumentation needs and security concerns will be addressed.
NGS Sequence Analysis
Speaker: Julie Hirschborn
Participants will be given an overview of sequence analysis and bioinformatics. Essential terminology will be defined and limitations and challenges discussed. Various approaches and their strengths and weaknesses will be explored.
From Start to Finish: Hands-on Design of NGS and Bioinformatics Practice—Part 1
Speaker: Stephanie Goya
Part 1 of this training—These hands-on sessions are a practical recapitulation on how to design a NGS experiment and the bioinformatic analysis in different scenarios, with special emphasis on the limitations and benefits of each development. These sessions are a debate space where attendees accompanied by a NGS expert will be able to reaffirm concepts seen in the previous webinars, solve doubts and ask questions of specific interest for their projects.
From Start to Finish: Hands-on Design of NGS and Bioinformatics Practice—Part 2
Speaker: Stephanie Goya
Part 2 of this training—These hands-on sessions are a practical recapitulation on how to design a NGS experiment and the bioinformatic analysis in different scenarios, with special emphasis on the limitations and benefits of each development. These sessions are a debate space where attendees accompanied by an NGS expert will be able to reaffirm concepts seen in the previous webinars, solve doubts and ask questions of specific interest for their projects.
Introduction to NGS Infrastructure
Speaker: Amy Mathers
Overview course providing information on the recommended laboratory components and computing requirements recommended to begin NGS applications. Recommendations on what to upgrade based on specific applications (graphics processing units [GPUs], central processing units [CPUs], memory, hard drives, etc.) will be provided, along with a discussion on local vs. high-performance computing (HPC) vs. cloud computing platforms.
Define Different Sequencing Techniques and Platforms
Speaker: Winston Timp
A practical and detail-oriented course exploring the 3 generations of nucleic acid sequencing technologies. The course will explore the strengths and weakness of the sequencing platforms, provide examples to guide choosing a sequencing approach for different biological questions and the expected data and file types that will be generated.
Next-Generation Sequencing in Microbiology: Pathogen and AMR Detection- Part 1
Speaker: Charles Chiu
Part 1 of this course—Introduction to targeted NGS and metagenomic approaches to classify pathogens.
Next-Generation Sequencing in Microbiology: Pathogen and AMR Detection—Part 2
Speaker: Charles Chiu
Part 2 of this course—Introduction to targeted NGS and metagenomic approaches to classify pathogens.
Maintaining Order in the Sequence Tsunami: Sequence Data Management for Clinical Microbiologists and Bioinformaticians
Speaker: Andrew Warren
Introduction into NGS data management.
Whole Genome Sequencing
Speaker: John Dekker
Detailed course into whole genome sequencing, including specific steps to generate the sequence data, how third generation sequencing impacts whole genome sequencing (WGS) projects and common challenges in analyzing/understanding WGS.
Accessing, Exploring and Using the Publicly Available Databases and National Sequence Archives for Clinical Microbiologists—Part 1
Speakers: Michael Feldgarden and Arjun Prasad
Part 1 of this training—Dive into accessing, exploring and using the publicly available databases and national sequence archives for clinical microbiologists, e.g., National Center for Biotechnology Information (NCBI) and Global Initiative on Sharing All Influenza Data (GISAID).
Accessing, Exploring and Using the Publicly Available Databases and National Sequence Archives for Clinical Microbiologists—Part 2
Speakers: Michael Feldgarden and Arjun Prasad
Part 2 of this training—Dive into accessing, exploring and using the publicly available databases and national sequence archives for clinical microbiologists, e.g., NCBI and GISAID.
Assessing Data Quality and Metrics—Part 1
Speaker: David Gaston
Advanced level practical course into sequence quality assurance/quality control (QA/QC), recommended cut offs and what to do when you need to work with lower quality sequence data.
Assessing Data Quality and Metrics—Part 2
Speaker: David Gaston
Advanced level practical course into sequence QA/QC, recommended cut offs and what to do when you need to work with lower quality sequence data.
Quality Control Requirements
Speaker: Emily Snavely
Follow-up course to "Assessing Data Quality and Metrics—Parts 1 and 2," including error rates between sequencing technologies and introduction into assessing genome quality.
Assay Design, Optimization and Validation—Part 1
Speaker: Trish Simner
Overview course on steps required to design and implement novel assays for clinical microbiologists. Will include a discussion on recommended sample sizes, troubleshooting steps and regulatory guidelines that can be useful/critical resources.
Assay Design, Optimization and Validation—Part 2
Speaker: Trish Simner
Overview course on steps required to design and implement novel assays for clinical microbiologists. Will include a discussion on recommended sample sizes, troubleshooting steps and regulatory guidelines that can be useful/critical resources.
Speaker: Heather Blankenship
Advanced course into the practical applications of NGS approaches, including targeted, amplicon and whole genome sequencing. This course will highlight differences in sequencing (wet-lab) components between the approaches.
Sequence Comparison and Phylogeny
Speaker: Kelly Oakeson
Practical-oriented course on the principles of pathogen identification and sequence comparison. Bioinformatics tools and approaches commonly used for these analyses, along with their benefits and limitations, will be discussed.
NGS of Cultured Fungal Pathogens
Speaker: Christina Cuomo
Advanced course into whole genome sequencing (WGS) approaches which leverage cultured fungal isolates, highlighting both wet-lab considerations and available bioinformatic tools/workflows.
Introduction to NGS Data Analysis Workflows
Speaker: Kelsey Florek
Practical course into reproducible workflows and recommended tools for NGS applications.
Metagenomic NGS Methods
Speaker: Kevin Chau
Advanced course on metagenomic approaches to analyze mixed communities without the need for isolation.
All About Trees: Sequence Comparison and Phylogeny
Speaker: Kelly Oakeson
Workshop participants will learn how to generate and interpret phylogenetic trees using open-source bioinformatic tools. Multiple real-world examples will be used to highlight benefits and limitations of phylogenetic tree interpretation.
Building NGS Data Analysis Workflows
Speaker: Robert Petit
In this hands-on activity, participants will learn how to use workflow management tools.
NGS of Cultured Bacterial and Mycobacterial Pathogens
Speaker: Emily Snavely
Advanced course into WGS approaches which leverage cultured bacterial and mycobacterial isolates. Wet-lab considerations, influence of pathogen characteristics on sequencing and common challenges to data analysis will be covered.
Speaker: Shaun Yang
Deeper overview in bacterial genome structure, mobile elements, genetic exchange mechanisms (horizontal gene transfer), recombination, etc.
Introduction to Clinical Virology and Viral Genomics
Speaker: P Hemarajata
Deeper discussion into viral genomes, challenges in ribonucleic acid (RNA) vs. deoxyribonucleic acid (DNA) and single stranded vs. double stranded genomes, range of mutation rates (and why) and how different sequencing technologies and library preps relate to characterizing viral sequences.
Specifics of Eukaryotic Genomics
Speaker: Bridget Barker
Deeper overview into eukaryotic genomes, including the range in sizes, gene arrangements and transcriptional complexity, repetitive elements and challenges in whole genome sequencing.
Antimicrobial Resistance and NGS—Part 1
Speaker: Hannah Gray
Advanced course on identifying and characterizing antimicrobial resistance markers. Part 1 focuses on multi-drug resistant organisms (MDRO), e.g. carbapenem-resistant Enterobacterales (CRE).
Antimicrobial Resistance and NGS—Part 2
Speaker: Kimberlee A. Musser
Advanced course on identifying and characterizing antimicrobial resistance markers. Part 2 focuses on tuberculosis (TB).
Bacterial or Fungal WGS Bioinformatics
Speaker: Robert Petit
Practical course for assembling whole genomes from data generated by different NGS platforms.
Hospital Infection Control
Speaker: Shaun Yang
Advanced practical course into using NGS data to identify, characterize and track healthcare-associated infections (HAIs). Lean on case studies to flush out real-world examples.
Bioinformatics with Terra.Bio: Direct-from-Specimen Approaches for Viral Genomic Characterization
Speaker: Frank Ambrosio
Advanced course into direct-from-specimen sequencing including pros/cons vs. isolation and sequencing. Focused on severe acute respiratory syndrome coronavirus 2 (SARS-CoV-2) and monkeypox virus (MPXV).
Molecular Evolution and Community Outbreak
Speaker: Allison Black
Advanced, practical course on NGS methods to provide contract tracing data and include a hands-on activity that reconstructs an outbreak scenario.
Funding is provided by the Centers for Disease Control and Prevention. Contract 75D30122c13310
Questions? Need assistance? Contact clinmicro@asmusa.org.